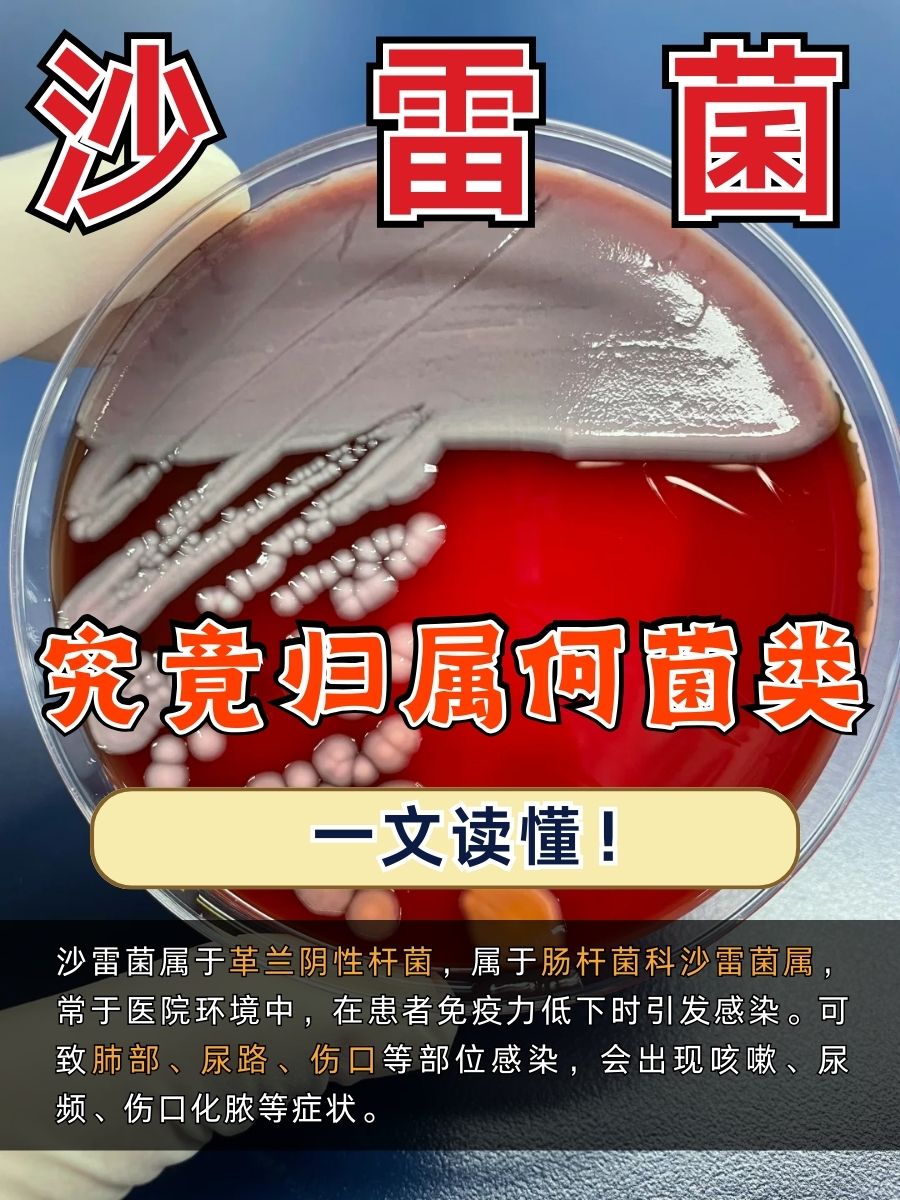
沙雷菌究竟归属何菌类?一文读懂!
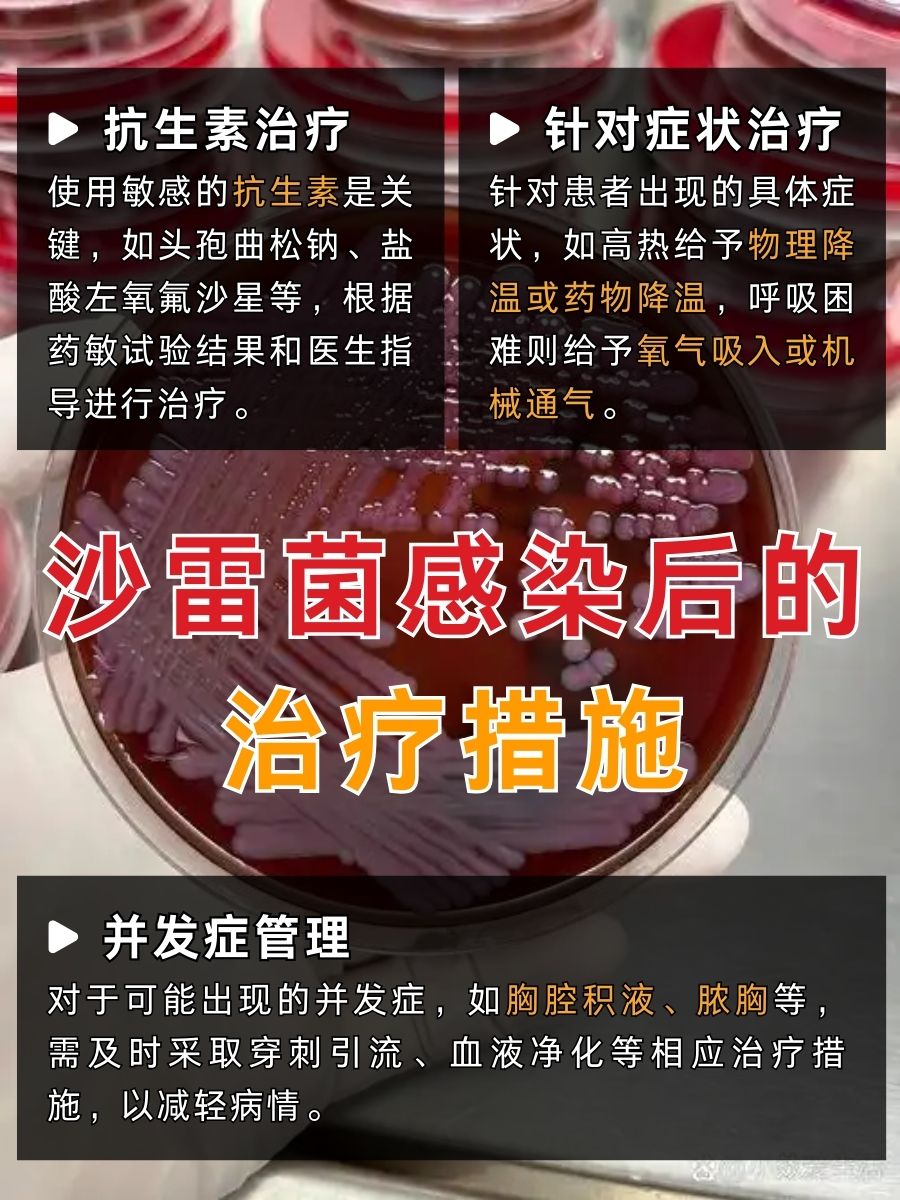
沙雷菌究竟归属何菌类?一文读懂!

🌟沙雷菌隶属于肠杆菌科沙雷菌属,是革兰氏阴性菌。这类细菌呈直杆状,大小约(0.5-1.0)μm×(1-3)μm,周身鞭毛,能运动,无芽孢,无荚膜。
🌿沙雷菌广泛分布于水、土壤、植物、动物以及人的肠道等环境中。其显著特点是部分菌株能产生灵菌红素,这是一种红色的色素,使得菌落呈现出鲜明的红色或粉红色,在实验室培养时易于识别。
😷沙雷菌作为条件致病菌,通常情况下不会对人体造成危害。然而,当人体免疫力下降,如长期患慢性疾病、接受免疫抑制剂治疗、遭受严重创伤或烧伤时,沙雷菌就可能乘虚而入,引起多种感染。
🌸肺部感染:沙雷菌可引发肺部感染,患者常出现咳嗽、发热、咳痰等症状,严重时可发展为肺炎。对于本身患有慢性呼吸道疾病的患者,由于呼吸道防御功能减弱,感染沙雷菌后病情往往更严重,治疗难度也更大。在医院病房,特别是重症监护室,患者抵抗力普遍较差,一旦感染沙雷菌引发肺炎,可能危及生命。
🌸尿路感染:沙雷菌易引发尿路系统感染,患者通常会出现尿频、尿急、尿痛等症状。长期留置导尿管的患者,尿道黏膜的防御机制被破坏,沙雷菌容易沿导尿管逆行进入尿路系统,引发感染,严重时可导致肾盂肾炎,损害肾脏功能。
🌸伤口部位感染:沙雷菌可导致伤口部位感染,尤其是在烧伤、手术切口等开放性伤口处。感染后伤口会出现红肿、化脓等症状,不仅延缓伤口愈合,还可能引发全身性感染,如败血症,严重威胁患者生命健康。
👍诊断沙雷菌感染主要依靠临床症状和实验室检查。医生根据症状怀疑感染后,采集痰液、尿液、伤口分泌物等标本进行培养,若培养出沙雷菌,并结合症状可确诊。然而,治疗沙雷菌感染面临严峻挑战,因其耐药性广泛,医生常需等待药敏试验结果来对症治疗,详情见图~预防措施也很重要,也附上了图片,方便查看,如果今天分分享对你有帮助的话,可以点赞+收藏,欢迎到评论区交流!